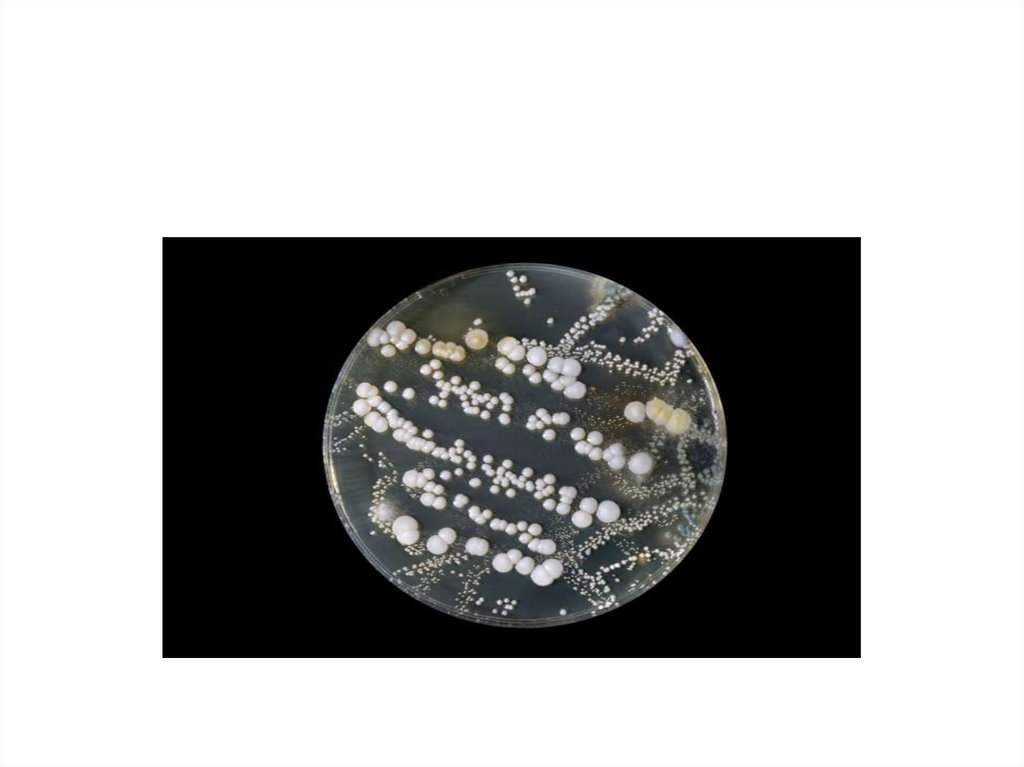

Похожие презентации:
Общая характеристика возбудителей раневых инфекций
1.
Общая характеристикавозбудителей раневых инфекций
2.
• Патогенные анаэробы относятся кСемейству Bacillaceae
Роду Clostridium.
3.
• Анаэробы - обширная группа микроорганизмов, среди которыхпатогенны для человека:
• 1) клостридии столбняка;
• 2) клостридии газовой гангрены (полимикробная инфекция);
• 3) клостридии ботулизма.
4.
Окраска по ГрамуПосев на КА
5.
• Патогенные анаэробы являются постоянными обитателямикишечника животных и человека,
• с испражнениями которых выделяются во внешнюю среду.
• В виде спор они длительно сохраняются в почве, морской и
пресной воде.
6.
• Морфология• Патогенные клостридии - крупные палочки размером 4-9 × 0,61,2 мкм
• Молодые культуры грамположительны, старые теряют
способность окрашиваться по Граму.
7.
8.
• Все клостридии образуют споры овальной или круглой формы,располагающиеся терминально, субтерминально и центрально.
9.
10.
• Большинство анаэробов подвижны.• Жгутики располагаются перитрихиально.
• Клостридии продуцируют экзотоксины высокой биологической
активности.
11.
Методы культивирования12.
• Культивируют анаэробы в без кислородных условиях.• Существует несколько способов удаления кислорода при их
культивировании:
• Физические;
• Химический
• Биологические;
13.
• Физические методы.• Удаление кислорода механическим путем. Удаление воздуха
осуществляется в анаэростате - герметически закрывающемся
приборе с устройством для откачивания воздуха.
14.
• Портативный (переносной) анаэростат - небольшой цилиндр сгерметически закрывающейся крышкой и краном для
откачивания воздуха.
15.
• Посевы устанавливают в анаэростат, создают вакуум в аппарате иставят в термостат.
• Этот аппарат может быть заменен эксикатором.
16.
• Культивирование в атмосфере инертного газа.• Воздух в анаэростате замещается азотом, смесью азота с
углекислым газом или водородом.
17.
• Культивирование в высоком столбике агара с глюкозой.• Микроорганизмы растут на дне, защищенные от воздуха
высоким слоем среды.
18.
• Биологические методы.• Совместное выращивание анаэробов и аэробов.
• В чашку Петри наливают толстым слоем агар с 5% крови. По
диаметру чашки делают в агаре желобок, чтобы культуры не
смешивались.
• На одну половину засевают культуру аэроба, на другую анаэроба.
19.
• Края чашки заливают парафином.• Посевы помещают в термостат.
• Сначала вырастают аэробы, после того как они поглощают весь
кислород, находящийся в чашке, начинают расти анаэробы.
20.
• Питательные среды:• Среда Китта - Тароцци.
• Кровяной агар.
• Среда Вильсона - Блера.
• Высокий столбик сахарного агара
21.
•Возбудитель столбняка• Clostridium tetani описал Николайер в 1884 г.
• В чистой культуре получил Китазато в 1889г.
22.
Окраска по Граму23.
• Морфология.• С. tetani - палочки размером 4-8 × 0,4-1 мкм с закругленными
краями. Подвижны. Жгутики располагаются перитрихиально.
Капсул не образуют.
• Образуют споры шаровидной формы, расположенные
терминально, что придает бацилле вид барабанной палочки.
24.
Расположение жгутиков и спор25.
• Культивирование.• Возбудитель столбняка - строгий анаэроб. Высокочувствителен к
кислороду.
• Поэтому палочки хорошо размножаются в глубине высокого
столбика агара.
Рисунок - Высокий
столбик сахарного
агара.
26.
• Перед посевом из среды удаляют кислород путем кипячения вводяной бане и быстрого охлаждения до температуры 40-50° С.
• Возбудители столбняка растут при температуре 35-37° С и рН
среды 6,8-7,4.
27.
• На плотных питательных средах рост появляется на 3-4-й день.• Выросшие колонии сероватого цвета, иногда прозрачные с
неровной зернистой поверхностью и вытянутыми краями - Rформа.
28.
29.
• В высоком столбике агара С. tetani образуютколонии в виде пушинок, иногда колонии бывают
темные и напоминают чечевичные зерна.
• На кровяных средах вокруг колоний отмечается зона
гемолиза.
30.
• При посеве возбудителей столбняка на среду Китта - Тароццисреда мутнеет.
• Рост на среде Вильсона-Блера характеризуется почернением
среды. Посевы на чашках ставят в анаэростат.
31.
32.
• Ферментативные свойства.• С. tetani обладают слабой ферментативной активностью.
Углеводы не расщепляют
33.
• Протеолитические свойства• выражаются в восстановлении нитратов в нитриты, медленном
свертывании молока и медленном разжижении желатина.
34.
• Токсинообразование.• С. tetani вырабатывают сильный экзотоксин, состоящий из двух
компонентов:
1.Тетаноспазмина
2.Тетанолизина.
35.
• Тетаноспазмин (нейротоксин) поражает двигательные клеткинервной ткани, что приводит к спазматическому сокращению
мышц.
• Тетанолизин гемолизирует эритроциты.
36.
• Антигенная структура.• Клостридии столбняка делят на 10 сероваров.
• Разделение на серовары производят по Н-антигену, а на
серогруппы - по О-антигену,
37.
• Устойчивость к факторам окружающей среды.• Вегетативные формы С. tetani при температуре 60-70° С погибают
через 20-30 мин.
• Споры обладают большой устойчивостью, они выдерживают
кипячение в течение 1-1,5 ч.
38.
• В почве и на других предметах споры длительно сохраняются.• Прямой солнечный свет убивает их через несколько часов.
39.
• Дезинфицирующие растворы:• 5% раствор фенола, 1% раствор формалина губит их через 5-6 ч.
40.
• Восприимчивость животных.• В естественных условиях столбняком болеют лошади и мелкий
рогатый скот.
• Из экспериментальных животных к столбнячному токсину высоко
чувствительны белые мыши, кролики, крысы.
41.
• Источники инфекции.• Возбудители столбняка широко распространены в природе.
• Многие животные являются носителями этих микроорганизмов,
поэтому С. tetani обнаруживают в почве, куда они попадают из
кишечника животных и человека.
42.
• Споры могут разноситься с пылью, попадая наодежду и другие предметы.
43.
• Пути передачи и входные ворота.• Входными воротами является поврежденная кожа и слизистые
оболочки.
• Столбняк является раневой инфекцией и заболеваемость
связана с травматизмом.
44.
• Патогенез.• Проникнув в глубину ткани, споры на месте внедрения начинают
прорастать в вегетативные формы.
• Размножаясь, столбнячная палочка выделяет экзотоксин
45.
• Наиболее ранними признаками являются судороги жевательныхмышц (тризм), затем начинается спазм лицевой и затылочной
мускулатуры.
• Появляется "сардоническая улыбка". Затем сокращаются мышцы
живота и нижних конечностей.
46.
47.
• Смерть наступает от асфиксии вследствие спазмадыхательной мускулатуры.
48.
• Иммунитет.• Постинфекционного иммунитета нет, так как исход этого
заболевания часто смертельный.
49.
• Специфическая профилактика.• Основана на иммунизации анатоксином, являющимся
компонентом АКДС.
• Прививки вакциной АКДС проводят всем детям в возрасте от 3-6
месяцев до 12 лет с последующей ревакцинацией,
50.
• Специфическое лечение.• Вводят внутримышечно противостолбнячную сыворотку.
51.
Возбудители газовой
гангрены
52.
• Газовая гангрена - это полимикробная инфекция, т. е. вызываетсягруппой микроорганизмов.
• Они относятся к семейству Bacillaceae, роду Clostridium.
53.
• Основные представители:• C. perfringens,
• C. novyi,
• C. septicum,
• C. histolyticum,
• C. sordellii.
54.
Clostridium perfringens
55.
• Морфология.• C. perfringens - крупные полиморфные палочки в среднем 3-9 ×
0,9-1,2 мкм.
• Неподвижны. Свежевыделенные из организма культуры имеют
капсулу
56.
• При попадании в неблагоприятные условия образуют спорыовальной формы, располагающиеся центрально или
субтерминально.
• Грамположительны. Старые культуры утрачивают способность
окрашиваться по Граму.
57.
• Культивирование.• C. perfringens - анаэробы, но не очень чувствительны к кислороду
воздуха.
• Они хорошо и быстро растут на питательных средах,
приготовленных из гидролизатов мяса или казеина: 3-8 ч при
температуре 37-42° С и рН среды 7,2-7,4.
58.
• Рост сопровождается бурным газообразованием и снижением рНв кислую сторону.
• На плотных питательных средах C. perfringens образуют
шероховатые R, гладкие S и слизистые М колонии
59.
• В жидких средах рост характеризуется равномернымпомутнением и газообразованием.
• На кровяных средах C. perfringens образуют зону гемолиза.
60.
• Ферментативные свойства –• C. perfringens сбраживают лактозу, глюкозу, сахарозу, мальтозу с
образованием кислоты и газа.
61.
• Протеолитические свойства –• свертывают молоко, медленно (2-7 дней) разжижают желатин.
62.
• C. perfringens продуцируют лецитиназу,гиалуронидазу, желатиназу, коллагеназу и другие
ферменты патогенности
63.
• Токсинообразование.• C. perfringens выделяют сложный экзотоксин.
64.
• Антигенная структура.• C. perfringens разделяют на пять сероваров, которые
обозначаются большими латинскими буквами А, В, С, D и Е.
65.
• Иммунитет.• После перенесенного заболевания остается непрочный
иммунитет.
• Более стойкий иммунитет создается при иммунизации
анатоксином.
66.
• Профилактика• осуществляется хирургической обработкой раны (иссечение,
разрезы).
• Для специфической профилактики используют адсорбированный
полианатоксин, содержащий анатоксины всех представителей
газовой гангрены.
67.
• Лечение.• Для специфического лечения применяют антитоксическую
сыворотку по 50000 ME каждого из клостридии, т. е. всего 150000
ME.
• Сыворотку вводят внутривенно.

Медицина
Медицина








